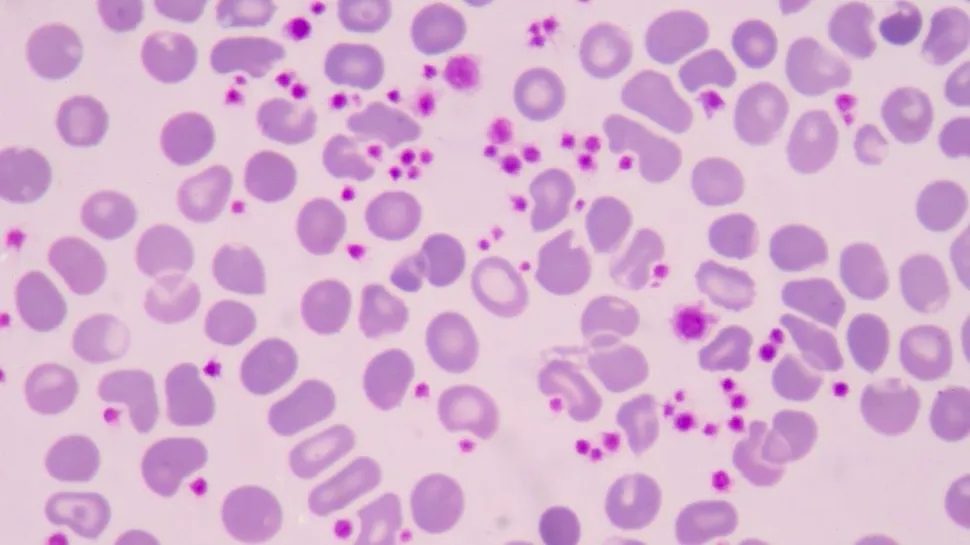
Understanding Thrombocytopenia in Myeloma image

Understanding Thrombocytopenia in Myeloma
What is Thrombocytopenia? What Causes It?
Thrombocytopenia is a medical condition in which there is a lower number of platelets in the blood than normal.
Platelets are tiny, colorless blood cells that play a crucial role in blood clotting. They help stop bleeding by clumping together at the site of an injury and forming a plug to seal off damaged blood vessels.
Thrombocytopenia can result from various underlying causes, such as:
- Decreased platelet production: Chemotherapy, other myeloma medications, or even myeloma itself can cause decreased platelet production.
- Increased platelet destruction: Some autoimmune disorders, infections, and medications can lead to the destruction of platelets by the immune system.
- Sequestration: In certain medical conditions, platelets can be sequestered (trapped) in the spleen, reducing their availability in the bloodstream.
- Dilutional thrombocytopenia: This can occur in conditions where the blood becomes diluted, such as during massive blood transfusions or after surgery.
- Vitamin deficiencies: Lack of vitamins, like vitamin B12 and folate, can affect platelet production.
Thrombocytopenia can manifest with various symptoms, depending on its severity. Mild cases may not cause noticeable symptoms, while more severe cases can lead to easy bruising, prolonged bleeding from minor cuts, nosebleeds, bleeding gums, and, in rare cases, internal bleeding.
Why Is There Thrombocytopenia in Multiple Myeloma?
In the context of multiple myeloma, thrombocytopenia can develop as a result of the disease itself or as a side effect of some treatments, such as chemotherapy.
In multiple myeloma, abnormal plasma cells can crowd out healthy blood-forming cells in the bone marrow, leading to decreased platelet production.
Additionally, certain medications used to treat multiple myeloma can suppress the bone marrow's ability to produce platelets, contributing to thrombocytopenia.
Managing thrombocytopenia involves addressing the underlying cause and, if necessary, using treatments like platelet transfusions or medications to stimulate platelet production.
It's important to work closely with healthcare professionals to monitor and manage this condition, especially in the case of multiple myeloma where thrombocytopenia can have additional implications for disease management and treatment.
What is Thromboembolism in Myeloma?
Thromboembolism refers to the formation of a blood clot (thrombus) that dislodges from its site of origin and travels through the bloodstream until it becomes lodged in a smaller blood vessel, obstructing blood flow.
In the context of multiple myeloma, thromboembolism is a significant concern due to the disease's impact on the blood and the overall clotting process.
Patients with multiple myeloma are at an increased risk of thromboembolism for several reasons:
- Hypercoagulable state: Multiple myeloma can disrupt the balance between procoagulant (clot-promoting) and anticoagulant (clot-preventing) factors in the blood, leading to a state of hypercoagulability. This increases the risk of abnormal clot formation.
- Abnormal proteins: The abnormal plasma cells in multiple myeloma can produce proteins that affect blood clotting and promote clot formation.
- Immobility: Cancer patients, including those with multiple myeloma, often experience periods of immobility due to illness, hospitalization, or treatment. Immobility is a risk factor for blood clot formation.
- Dehydration: Multiple myeloma can lead to dehydration, which thickens the blood and increases the risk of clot formation.
- Medications: Some medications used in the treatment of multiple myeloma, such as thalidomide and lenalidomide, can further increase the risk of blood clot formation.
Thromboembolism can have serious consequences, depending on where the clot lodges.
If a clot obstructs a blood vessel in the lungs (pulmonary embolism), it can lead to difficulty breathing, chest pain, and in severe cases, even death.
If it occurs in a deep vein (deep vein thrombosis), it can cause pain, swelling, and potential complications if the clot breaks free and travels to the lungs.
Due to the increased risk of thromboembolism in multiple myeloma, doctors often take preventive measures. This may include prescribing blood-thinning medications (anticoagulants) or aspirin to reduce the risk of clot formation.
It's essential for individuals with multiple myeloma to communicate closely with their healthcare team, report any symptoms of clotting or bleeding, and adhere to recommended preventive strategies and treatments to manage this risk effectively.
Is ITP Related to Multiple Myeloma?
ITP, or immune thrombocytopenic purpura, is not directly related to multiple myeloma, but both conditions can involve disruptions in platelet levels and function.
ITP is an autoimmune disorder where the immune system mistakenly targets and destroys platelets in the blood, leading to low platelet counts (thrombocytopenia). This can result in increased risk of bleeding, easy bruising, and petechiae (small, red or purple spots on the skin).
Multiple myeloma, on the other hand, is a cancer of plasma cells in the bone marrow. It primarily affects the production of antibodies and can disrupt the balance of different blood cells, including platelets. While multiple myeloma doesn't cause ITP, it can lead to various complications related to blood cell production, including thrombocytopenia.
In some cases, both conditions can coexist in the same individual, although this is rare. It's important for healthcare professionals to thoroughly evaluate patients with low platelet counts to determine the underlying cause. If multiple myeloma and ITP are both present, the treatment approach would likely involve addressing both conditions separately and as part of a comprehensive care plan.
Remember that medical conditions can vary widely, and each patient's situation is unique. If you or someone you know is experiencing low platelet counts or related symptoms, it's important to seek medical advice for proper diagnosis and management.
Thrombocytopenia (Low Platelet Count) Resources
What is Thrombocytopenia? What Causes It?
Thrombocytopenia is a medical condition in which there is a lower number of platelets in the blood than normal.
Platelets are tiny, colorless blood cells that play a crucial role in blood clotting. They help stop bleeding by clumping together at the site of an injury and forming a plug to seal off damaged blood vessels.
Thrombocytopenia can result from various underlying causes, such as:
- Decreased platelet production: Chemotherapy, other myeloma medications, or even myeloma itself can cause decreased platelet production.
- Increased platelet destruction: Some autoimmune disorders, infections, and medications can lead to the destruction of platelets by the immune system.
- Sequestration: In certain medical conditions, platelets can be sequestered (trapped) in the spleen, reducing their availability in the bloodstream.
- Dilutional thrombocytopenia: This can occur in conditions where the blood becomes diluted, such as during massive blood transfusions or after surgery.
- Vitamin deficiencies: Lack of vitamins, like vitamin B12 and folate, can affect platelet production.
Thrombocytopenia can manifest with various symptoms, depending on its severity. Mild cases may not cause noticeable symptoms, while more severe cases can lead to easy bruising, prolonged bleeding from minor cuts, nosebleeds, bleeding gums, and, in rare cases, internal bleeding.
Why Is There Thrombocytopenia in Multiple Myeloma?
In the context of multiple myeloma, thrombocytopenia can develop as a result of the disease itself or as a side effect of some treatments, such as chemotherapy.
In multiple myeloma, abnormal plasma cells can crowd out healthy blood-forming cells in the bone marrow, leading to decreased platelet production.
Additionally, certain medications used to treat multiple myeloma can suppress the bone marrow's ability to produce platelets, contributing to thrombocytopenia.
Managing thrombocytopenia involves addressing the underlying cause and, if necessary, using treatments like platelet transfusions or medications to stimulate platelet production.
It's important to work closely with healthcare professionals to monitor and manage this condition, especially in the case of multiple myeloma where thrombocytopenia can have additional implications for disease management and treatment.
What is Thromboembolism in Myeloma?
Thromboembolism refers to the formation of a blood clot (thrombus) that dislodges from its site of origin and travels through the bloodstream until it becomes lodged in a smaller blood vessel, obstructing blood flow.
In the context of multiple myeloma, thromboembolism is a significant concern due to the disease's impact on the blood and the overall clotting process.
Patients with multiple myeloma are at an increased risk of thromboembolism for several reasons:
- Hypercoagulable state: Multiple myeloma can disrupt the balance between procoagulant (clot-promoting) and anticoagulant (clot-preventing) factors in the blood, leading to a state of hypercoagulability. This increases the risk of abnormal clot formation.
- Abnormal proteins: The abnormal plasma cells in multiple myeloma can produce proteins that affect blood clotting and promote clot formation.
- Immobility: Cancer patients, including those with multiple myeloma, often experience periods of immobility due to illness, hospitalization, or treatment. Immobility is a risk factor for blood clot formation.
- Dehydration: Multiple myeloma can lead to dehydration, which thickens the blood and increases the risk of clot formation.
- Medications: Some medications used in the treatment of multiple myeloma, such as thalidomide and lenalidomide, can further increase the risk of blood clot formation.
Thromboembolism can have serious consequences, depending on where the clot lodges.
If a clot obstructs a blood vessel in the lungs (pulmonary embolism), it can lead to difficulty breathing, chest pain, and in severe cases, even death.
If it occurs in a deep vein (deep vein thrombosis), it can cause pain, swelling, and potential complications if the clot breaks free and travels to the lungs.
Due to the increased risk of thromboembolism in multiple myeloma, doctors often take preventive measures. This may include prescribing blood-thinning medications (anticoagulants) or aspirin to reduce the risk of clot formation.
It's essential for individuals with multiple myeloma to communicate closely with their healthcare team, report any symptoms of clotting or bleeding, and adhere to recommended preventive strategies and treatments to manage this risk effectively.
Is ITP Related to Multiple Myeloma?
ITP, or immune thrombocytopenic purpura, is not directly related to multiple myeloma, but both conditions can involve disruptions in platelet levels and function.
ITP is an autoimmune disorder where the immune system mistakenly targets and destroys platelets in the blood, leading to low platelet counts (thrombocytopenia). This can result in increased risk of bleeding, easy bruising, and petechiae (small, red or purple spots on the skin).
Multiple myeloma, on the other hand, is a cancer of plasma cells in the bone marrow. It primarily affects the production of antibodies and can disrupt the balance of different blood cells, including platelets. While multiple myeloma doesn't cause ITP, it can lead to various complications related to blood cell production, including thrombocytopenia.
In some cases, both conditions can coexist in the same individual, although this is rare. It's important for healthcare professionals to thoroughly evaluate patients with low platelet counts to determine the underlying cause. If multiple myeloma and ITP are both present, the treatment approach would likely involve addressing both conditions separately and as part of a comprehensive care plan.
Remember that medical conditions can vary widely, and each patient's situation is unique. If you or someone you know is experiencing low platelet counts or related symptoms, it's important to seek medical advice for proper diagnosis and management.
Thrombocytopenia (Low Platelet Count) Resources

about the author
Audrey Burton-Bethke
Audrey is a content writer and editor for the HealthTree Foundation. She originally joined the HealthTree Foundation in 2020. Audrey loves spending time with her supportive husband, energetic four-year-old, and new baby.
More on Core Education
Trending Articles





Get the Latest Multiple Myeloma Updates, Delivered to You.
By subscribing to the HealthTree newsletter, you'll receive the latest research, treatment updates, and expert insights to help you navigate your health.